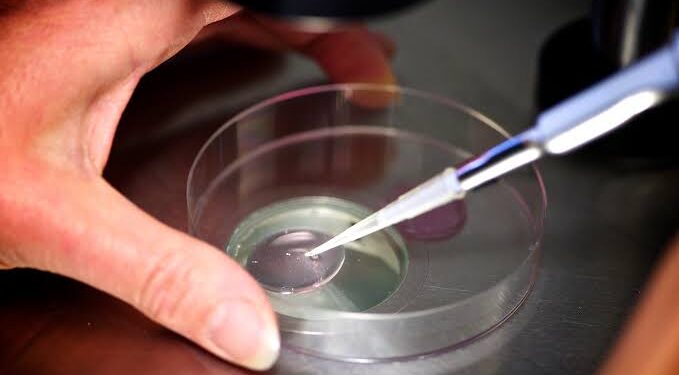
IVF clinic admits embryo mix-up as mother gives birth to another patient’s baby

An Australian IVF clinic has admitted a mix-up led to a mother giving birth to someone else’s baby.
The clinic said the embryo which was “incorrectly transferred” to another patient who later gave birth was a human error
“I want to say how truly sorry I am for what has happened,” Monash IVF chief executive Michael Knaap said in a statement late Thursday.
“All of us at Monash IVF are devastated and we apologise to everyone involved. We will continue to support the patients through this extremely distressing time.”
The mistake was discovered in February after the child’s parents asked for their remaining embryos in storage to be transferred to another IVF provider.
Staff found one more embryo than they expected.
That sparked an immediate investigation, which found that an embryo from a different patient had been “incorrectly thawed” and transferred to the mother.
“The investigation also found that despite strict laboratory safety protocols being in place, including multi-step identification processes being conducted, a human error was made.”
Monash IVF said it informed the affected patients within a week to apologise and offer support.
Identities were not disclosed to protect the privacy of the patients and the child.
Australia’s social services minister, Amanda Rishworth, said Friday it was “imperative” that confidence be restored after the embryo mix-up.
“As someone that had a baby through IVF, it absolutely breaks my heart,” she told Channel Nine television.
“I cannot imagine the distress that this family or families are going through. You put so much trust in these companies.”
Queensland Health said it became aware of the error in February but the incident happened before it became the state’s assisted reproductive technology regulator in September 2024.
“We will work with Monash IVF to reinforce safeguards in their Queensland clinics and ensure any risks are identified and mitigated,” it said.
In August last year, Monash IVF agreed to pay Aus$56 million (US$36 million), without admitting liability, to settle a class action suit alleging it may have destroyed viable embryos because faulty genetic testing wrongly classified them as abnormal.